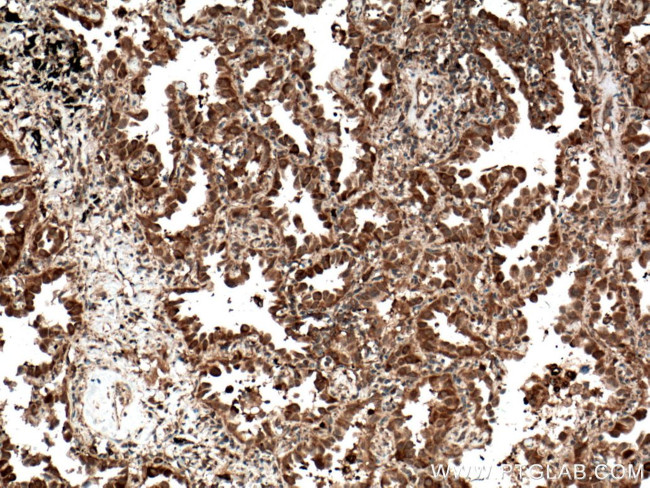
C21orf2 Antibody in Immunohistochemistry (Paraffin) (IHC (P))
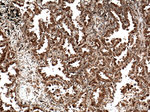
C21orf2 Antibody in Immunohistochemistry (Paraffin) (IHC (P))

Search
Proteintech
C21orf2 Polyclonal Antibody
{{$productOrderCtrl.translations['antibody.pdp.commerceCard.promotion.promotions']}}
{{$productOrderCtrl.translations['antibody.pdp.commerceCard.promotion.viewpromo']}}
{{$productOrderCtrl.translations['antibody.pdp.commerceCard.promotion.promocode']}}: {{promo.promoCode}} {{promo.promoTitle}} {{promo.promoDescription}}. {{$productOrderCtrl.translations['antibody.pdp.commerceCard.promotion.learnmore']}}
产品信息
27609-1-AP
种属反应
宿主/亚型
分类
类型
抗原
偶联物
形式
浓度
规格
纯化类型
保存液
内含物
保存条件
运输条件
产品详细信息
Immunogen sequence: MKLTRKMVL TRAKASELHS VRKLNCWGSR LTDISICQEM PSLEVITLSV NSISTLEPVS RCQRLSELYL RRNRIPSLAE LFYLKGLPRL RVLWLAENPC CGTSPHRYRM TVLRTLPRLQ KLDNQAVTEE ELSRALSEGE EITAAPEREG TGHGGPKLCC TLSSLSSAAE TGRDPLDSEE EATSGAQDER GLKPPSRGQF PSLSARDASS SHRGRNVLTA ILLLLRELDA EGLEAVQQTV GSRLQALRGE EVQEHAE (1-256 aa encoded by BC072012)
靶标信息
Four alternatively spliced transcript variants encoding four different isoforms have been found for this nuclear gene. All isoforms contain leucine-rich repeats. Three of these isoforms are mitochondrial proteins and one of them lacks the target peptide, so is not located in mitochondrion. This gene is down-regulated in Down syndrome (DS) brain, which may represent mitochondrial dysfunction in DS patients.
仅用于科研。不用于诊断过程。未经明确授权不得转售。
生物信息学
蛋白别名: C21orf-HUMF09G8.5; cDNA A2-YF5; Cilia- and flagella-associated protein 410; cu002; leucine rich repeat containing 76; Leucine-rich repeat-containing protein 76; protein C21orf2; YF5; YF5/A2
基因别名: C21orf2; CFAP410; LRRC76; RDMS; SMDAX; YF5/A2
UniProt ID: (Human) O43822
Entrez Gene ID: (Human) 755